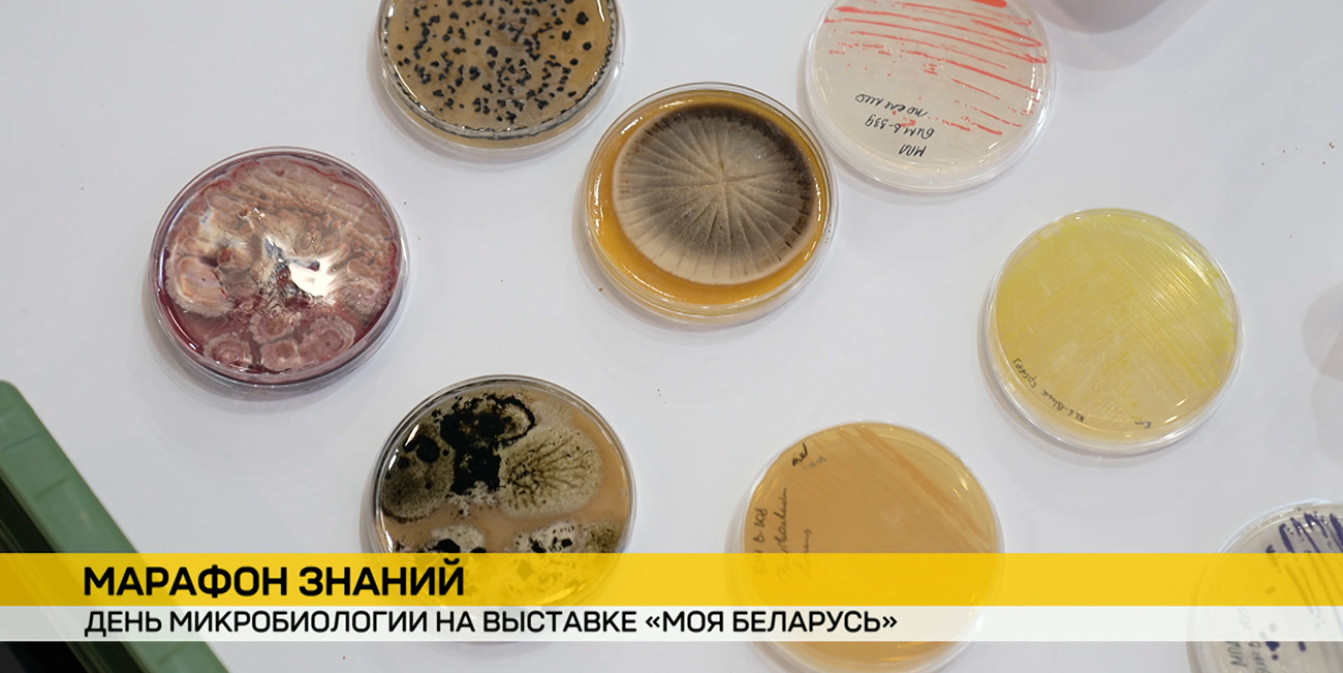

Марафон знаний: на выставке «Моя Беларусь» прошел День микробиологии
1 февраля на выставке «Моя Беларусь» в столице прошел День микробиологии в рамках Марафона знаний. Мероприятие объединило ученых, студентов и любознательных гостей, чтобы в доступной форме рассказать о роли микробиологии в современной науке и повседневной жизни.
Сотрудники Института микробиологии подготовили насыщенную программу. Здесь каждый смог окунуться в мир микроорганизмов и узнать что-то интересное. Не только лекции, но и интерактивы, интеллектуальные квизы. Победителям – призы.
Главный подарок – увидеть загадочный мир с другой стороны.
Узнать больше о грибах, плесени и о том, какие фабрики создают микроорганизмы. Уникальные лекции проходят в Международном выставочном центре каждые выходные.












